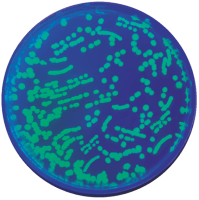
Transformation of bacteria with GFP. ©Edvotek 2014

The 2013-14 school year is wrapping up, and we’re sure that you (and your students) are anxiously counting down the minutes. However, whereas your students will get to leave all thoughts of class behind for the summer, we know you’ll be working to set up new classes or trying to incorporate new experiments into your existing curriculum. Below are some common questions and helpful hints to get you started for next fall:
I’d like to try to “flip” the classroom for a few lessons this year. Where do I get started?
So, let’s step back for a moment – for those of us that aren’t familiar with this, “flipping the classroom” is a teaching strategy that takes advantage of our ever more connected students. In the flipped classroom, teaching takes place at home online in the form of recorded mini-lectures or class chat rooms. In-class time can be spent learning through inquiry, in the form of collaborative projects like laboratory experiments. Biotechnology lends itself to the flipped classroom because so many of the experiments are inquiry-based, putting your students in the driver’s seat.
I’d like to cover transformation with my students next year, but I’ve never done any of these experiments before. What do I need to get started?
Transformation is the process through which some species of bacteria can acquire exogenous DNA from the surrounding environment. The newly acquired genetic information is both stable and heritable. In the laboratory, scientists can take advantage of this ability using small, circular pieces of DNA called plasmids. In nature, these plasmids allow bacteria to exchange useful genes. In the laboratory, these plasmids are engineered to contain genes from different sources. Once transformed into bacteria, the plasmids turn the bacteria into living factories to create useful products. Many biological medications are created in this fashion.
If you’re going to perform this experiment with your students, you’ll need two waterbaths (37°C and 42°C), thermometers, a bacterial incubator (37°C), pipet pumps or bulbs, and ice buckets. We recommend preparing the media in a microwave, but a Bunsen burner and a beaker of water will suffice. Some reagents need to be frozen, so you will need to have freezer storage in your classroom as well.
More importantly, if you’re just starting with transformation, I highly recommend transforming the bacteria with a plasmid that contains the Green Fluorescent Protein gene(GFP). After performing the experiment, the transformed bacteria will glow bright green using a long-wave UV light. Your students will be dazzled!
I’m teaching genetics and I want to bring more technology into my classroom. What is a good way to do this?
If you’re teaching genetics, one topic that I’m sure you’re covering extensively is the relationship between gene sequence and function. DNA sequence differences occur at specific locations throughout an organism’s genome. These mutations include single base pair changes, transposon insertions, and repetitive DNA elements. Although many of these mutations have no obvious phenotype, those that disrupt a gene or its regulatory sequences can cause changes in the way an organism appears, develops, or interacts with its environment.
In the early 1900’s, Thomas Hunt Morgan used eye color mutants to discover the relationship between genes and chromosomes. While sorting through his flies, he identified a single white-eyed male among the red-eyed flies. This mutation, called white-1, was the first genetic mutant identified in Drosophila. Morgan would use this white-eyed fly

in several test crosses to determine that the master gene for eye color was located on the X-chromosome, providing the first evidence of a gene being linked to a specific chromosome.
Today, we can put a modern spin on Morgan’s Nobel Prize-winning work using the polymerase chain reaction, or PCR. After extracting DNA from both wild-type and white-1 flies, your students will use PCR to amplify the region of the fly’s genome that is responsible for the difference in eye color. This experiment reinforces the relationship between genotype and phenotype in a fun, hands-on way.
